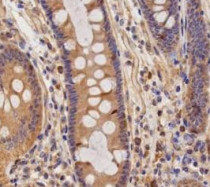

ARG44957
anti-TECPR1 antibody
anti-TECPR1 antibody for IHC-Formalin-fixed paraffin-embedded sections and Human
Overview
| Product Description | Mouse Monoclonal antibody recognizes TECPR1 |
|---|---|
| Tested Reactivity | Hu |
| Tested Application | IHC-P |
| Host | Mouse |
| Clonality | Monoclonal |
| Isotype | IgG2b |
| Target Name | TECPR1 |
| Antigen Species | Human |
| Epitope | KVWFRRGVNS HNPCGTSWIE MVGEMTMVNV GMNDQVWGIG CEDRAVYFRQ GVTPSELSGK TWKAIIAARE CDRSHSGSSS SLLSAGCFFG DEVRGSGESA PSDTDASSEV ERPGPGQILP AEPLDDSKNA TGNSASGLGA GRTAEDTVED ACPAEGSREA |
| Conjugation | Un-conjugated |
| Alternate Names | TECPR1; Tectonin Beta-Propeller Repeat Containing 1; KIAA1358 Tectonin Beta-Propeller Repeat-Containing Protein 1; DKFZP434B0335; FLJ23419; FLJ90593 |
Application Instructions
| Application Suggestion |
|
||||
|---|---|---|---|---|---|
| Application Note | * The dilutions indicate recommended starting dilutions and the optimal dilutions or concentrations should be determined by the scientist. |
Properties
| Form | Liquid |
|---|---|
| Purification | Protein A purification |
| Buffer | PBS with 0.09% sodium azide |
| Preservative | 0.09% sodium azide |
| Storage Instruction | For continuous use, store undiluted antibody at 2-8°C for up to a week. For long-term storage, aliquot and store at -20°C or below. Storage in frost free freezers is not recommended. Avoid repeated freeze/thaw cycles. Suggest spin the vial prior to opening. The antibody solution should be gently mixed before use. |
| Note | For laboratory research only, not for drug, diagnostic or other use. |
Bioinformation
| Database Links |
Swiss-port # Q7Z6L1 Human Tectonin beta-propeller repeat-containing protein 1 |
|---|---|
| Gene Symbol | TECPR1 |
| Gene Full Name | Tectonin Beta-Propeller Repeat Containing 1 |
| Background | This gene encodes a tethering factor involved in autophagy. The encoded protein is found at autolysosomes, and is involved in targeting protein aggregates, damaged mitochondria, and bacterial pathogens for autophagy [provided by RefSeq, Nov 2012] |
| Function | Tethering factor involved in autophagy. Involved in autophagosome maturation by promoting the autophagosome fusion with lysosomes: acts by associating with both the ATG5-ATG12 conjugate and phosphatidylinositol-3-phosphate (PtdIns3P) present at the surface of autophagosomes. Also involved in selective autophagy against bacterial pathogens, by being required for phagophore/preautophagosomal structure biogenesis and maturation. [UniProt] |
| Cellular Localization | Cytoplasmic vesicle, Lysosome, Membrane. [UniProt] |
| PTM | Phosphoprotein. [UniProt] |
Images (1) Click the Picture to Zoom In